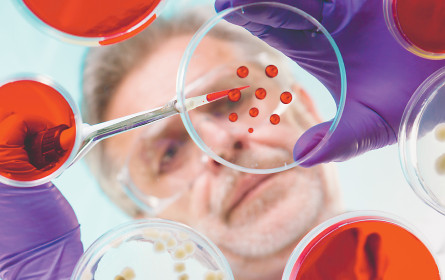
Pharmaindustrie steht vor weiteren Megadeals

Übernahmewelle Beobachter rechnen mit weiteren Megadeals in der Pharmabranche in den kommenden Monaten. Zum einen sind die Kriegskassen prall gefüllt, zum anderen wird Forschung immer aufwendiger und risikoreicher.
Wien. In der Pharmabranche steht die nächste milliardenschwere Übernahme an: Der Botox-Hersteller Allergan will den Konkurrenten Kythera Biopharmaceuticals kaufen. Allergan teilte mit, der Deal habe einen Wert von 2,1 Mrd. USD, das sind umgerechnet rund 1,9 Mrd. €, und solle teilweise in Aktien und in bar beglichen werden. Kythera ist für Allergan vor allem wegen kosmetischer Produkte interessant, mit denen auch ohne Operation Fett unterhalb des Kinns reduziert werden kann.
Je Kythera-Aktie bietet Allergan 75 USD. Das entspricht einem Aufschlag von 23,5% auf den aktuellen Kythera-Schlusskurs am Tag des Vertragsabschlusses in der Vorwoche. Gleich am nächsten Tag sprangen die Anteilsscheine nach Ankündigung der Transaktion im vorbörslichen US-Handel um knapp 23% nach oben.
Für Allergan ist es die erste große Übernahme, seit das US-amerikanische Unternehmen selbst für 66 Mrd. USD von dem irischen Konkurrenten Actavis aufgekauft wurde. Dieses hat daraufhin den Namen des Botox-Herstellers angenommen. Kythera ist ebenfalls in den USA angesiedelt.
Machtverhältnisse ordnen
Der Deal reiht sich in eine Reihe von Übernahmen: In der weltweiten Pharmabranche werden gerade die Machtverhältnisse mit zahlreichen Zukäufen neu geordnet. Unter anderem treiben hohe Forschungskosten und der Ablauf von Patenten auf lukrative Medikamente die Übernahmewelle an. Und diese ist nicht nur momentan sichtbar: Sie wird einer Studie zufolge im gesamten laufenden Jahr weiter rollen. Im ersten Quartal kauften Pharmakonzerne weltweit für fast 100 Mrd. € zu, wie aus einer kürzlich publizierten Analyse der Unternehmensberatung EY hervorgeht. „Wir können erwarten, dass sich dieser Boom fortsetzt”, sagte der Leiter des deutschen Life-Sciences-Geschäfts von EY, Siegfried Bialojan.
Bis Ende des Jahres dürfte der Wert der Transaktionen auf 201 Mrd. € steigen. Dabei gehen die Experten vor allem von weiteren Portfoliobereinigungen aus. „Es ist schwer denkbar, dass wir große Mega-Merger sehen werden, eher Verschiebungen von Aktivitäten”, sagte EY-Partner Gerd Stürz. „Es gibt nämlich einen klaren Trend zum Fokus auf die Kernkompetenzen.”
Ein Beispiel dafür war zuletzt das milliardenschwere Tauschgeschäft von GlaxoSmithKline und Novartis: Die Schweizer übernahmen das Krebsgeschäft des britischen Pharmakonzerns und dieser wiederum die Novartis-Impfstoffsparte. Vor allem die großen Pharmakonzerne stünden in den nächsten Jahren unter Druck, mit dem Wachstum des weltweiten Arzneimittelmarkts mitzuhalten, erklärte Bialojan. Mit Zukäufen könnte diese Lücke geschlossen werden.
Mehr Umsatz und Gewinn
Im vergangenen Jahr konnten die weltweit 20 größten Pharmaunternehmen, die der Studie zufolge von Novartis, Pfizer, Roche und Merck&Co angeführt werden, ihren Umsatz und den operativen Gewinn deutlich ausbauen. Dabei hätten sie erheblich von Kos-tensenkungen und Restrukturierungsmaßnahmen profitiert. Für weiteres Wachstum dürften auch neue Wirkstoffe sorgen: Insgesamt habe die Zahl der Wirkstoffe in der Entwicklung im vergangenen Jahr um fast 30% auf 3.592 zulegt. Von diesen befindet sich der Großteil aber noch in der frühen klinischen Erprobung; die Unternehmen konzentrieren sich dabei vor allem auf Medikamente gegen Krebs und Immunkrankheiten, fast jeder zweite Wirkstoff in der Entwicklung kommt aus diesen Therapiefeldern. Sie sind für die Firmen auch die größten Umsatzbringer.
„Im Jahr 2014 haben wir die Grenze von einer Billion US-Dollar im globalen Pharmaumsatz überschritten”, berichtet Erika Sander von IMS Health Österreich. Bis 2018 sagen die Marktforscher eine jährliche Wachstumsrate von vier bis sieben Prozent voraus. 2018 werde der globale Pharmaumsatz bei 1,3 Billionen USD liegen. Getrieben werde dieses Wachstum vor allem vom US-Pharmamarkt, der 35% des globalen Markts ausmacht. Für den US-Markt wird ein Wachstum von fünf bis acht Prozent prognostiziert, für den europäischen Markt sind die Prognosen etwas düsterer; Österreichs Pharmamarkt soll bis 2018 nur um Null bis drei Prozent wachsen.